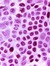
Béatric...

1,970 books
—
5,993 voters
Alexe Thériault
https://www.goodreads.com/alexee24
“Kaz leaned back. "What's the easiest way to steal a man's wallet?"
"Knife to the throat?" asked Inej.
"Gun to the back?" said Jesper.
"Poison in his cup?" suggested Nina.
"You're all horrible," said Matthias.”
― Six of Crows
"Knife to the throat?" asked Inej.
"Gun to the back?" said Jesper.
"Poison in his cup?" suggested Nina.
"You're all horrible," said Matthias.”
― Six of Crows
“Then let the world know that my first act of freedom was to help my friends.”
― House of Earth and Blood
― House of Earth and Blood
“...it is sad, of course, to forget.
But it is a lonely thing, to be forgotten.
To remember when no one else does.”
― The Invisible Life of Addie LaRue
But it is a lonely thing, to be forgotten.
To remember when no one else does.”
― The Invisible Life of Addie LaRue
“Blink and you’re twenty-eight, and everyone else is now a mile down the road, and you’re still trying to find it, and the irony is hardly lost on you that in wanting to live, to learn, to find yourself, you’ve gotten lost.”
― The Invisible Life of Addie LaRue
― The Invisible Life of Addie LaRue
Nothing But Reading Challenges
— 26773 members
— last activity 2 hours, 59 min ago
(click on image to go to discussion) We believe reading is fun and find unique and challenging ways to spread the love of reading. The a ...more
EVERYONE Has Read This but Me - The Catch-Up Book Club
— 28512 members
— last activity 19 hours, 21 min ago
Click HERE for the latest group announcements. "It reminded me of ____ but in space." "I read ____ in high school, and actually liked it." "It's ...more
Alexe’s 2025 Year in Books
Take a look at Alexe’s Year in Books, including some fun facts about their reading.
More friends…
Favorite Genres
Polls voted on by Alexe
Lists liked by Alexe